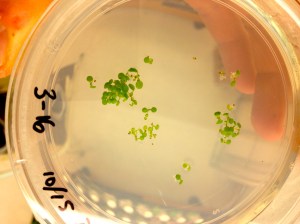
IMG_0747

Abstract: Many people struggle with genetic disorders that limit their ability to function as normal human beings. Although there are no true cures, some genetic disorders are treatable and manageable. One such example is Fabry disorder or Fabry’s Disease, which can be treated by giving patients regular enzyme infusions of the deficient enzyme. This rehabilitation process is aptly named enzyme replacement therapy (ERT), and it involves giving effected individuals supplemental doses of an enzyme called human a-Galactosidase-A (hGLA) enzyme, which they are unable to produce themselves. However, this type of therapy is extremely costly, and it’s dependent upon an efficient method that can produce large quantities of functional enzyme. The goal of my research is to test the efficiency of the plant Arabidopsis thaliana as an enzyme bio-reactor, and to evaluate whether protein production in plants could provide an effective alternate method to the current approach that utilizes animal cell culture. My predecessor, Katie Lantz, a graduate of Dr. Minocha’s lab, has demonstrated A. thaliana’s ability to produce hGLA. The current research is intended to test if the transferred gene is being expressed in the plants. The next steps will be to purify the protein and to test its functionality as an active enzyme. The success of this research will demonstrate a cost efficient, alternative method for ERT, and possibly provide a better the treatment option for patients with Fabry’s Disease.